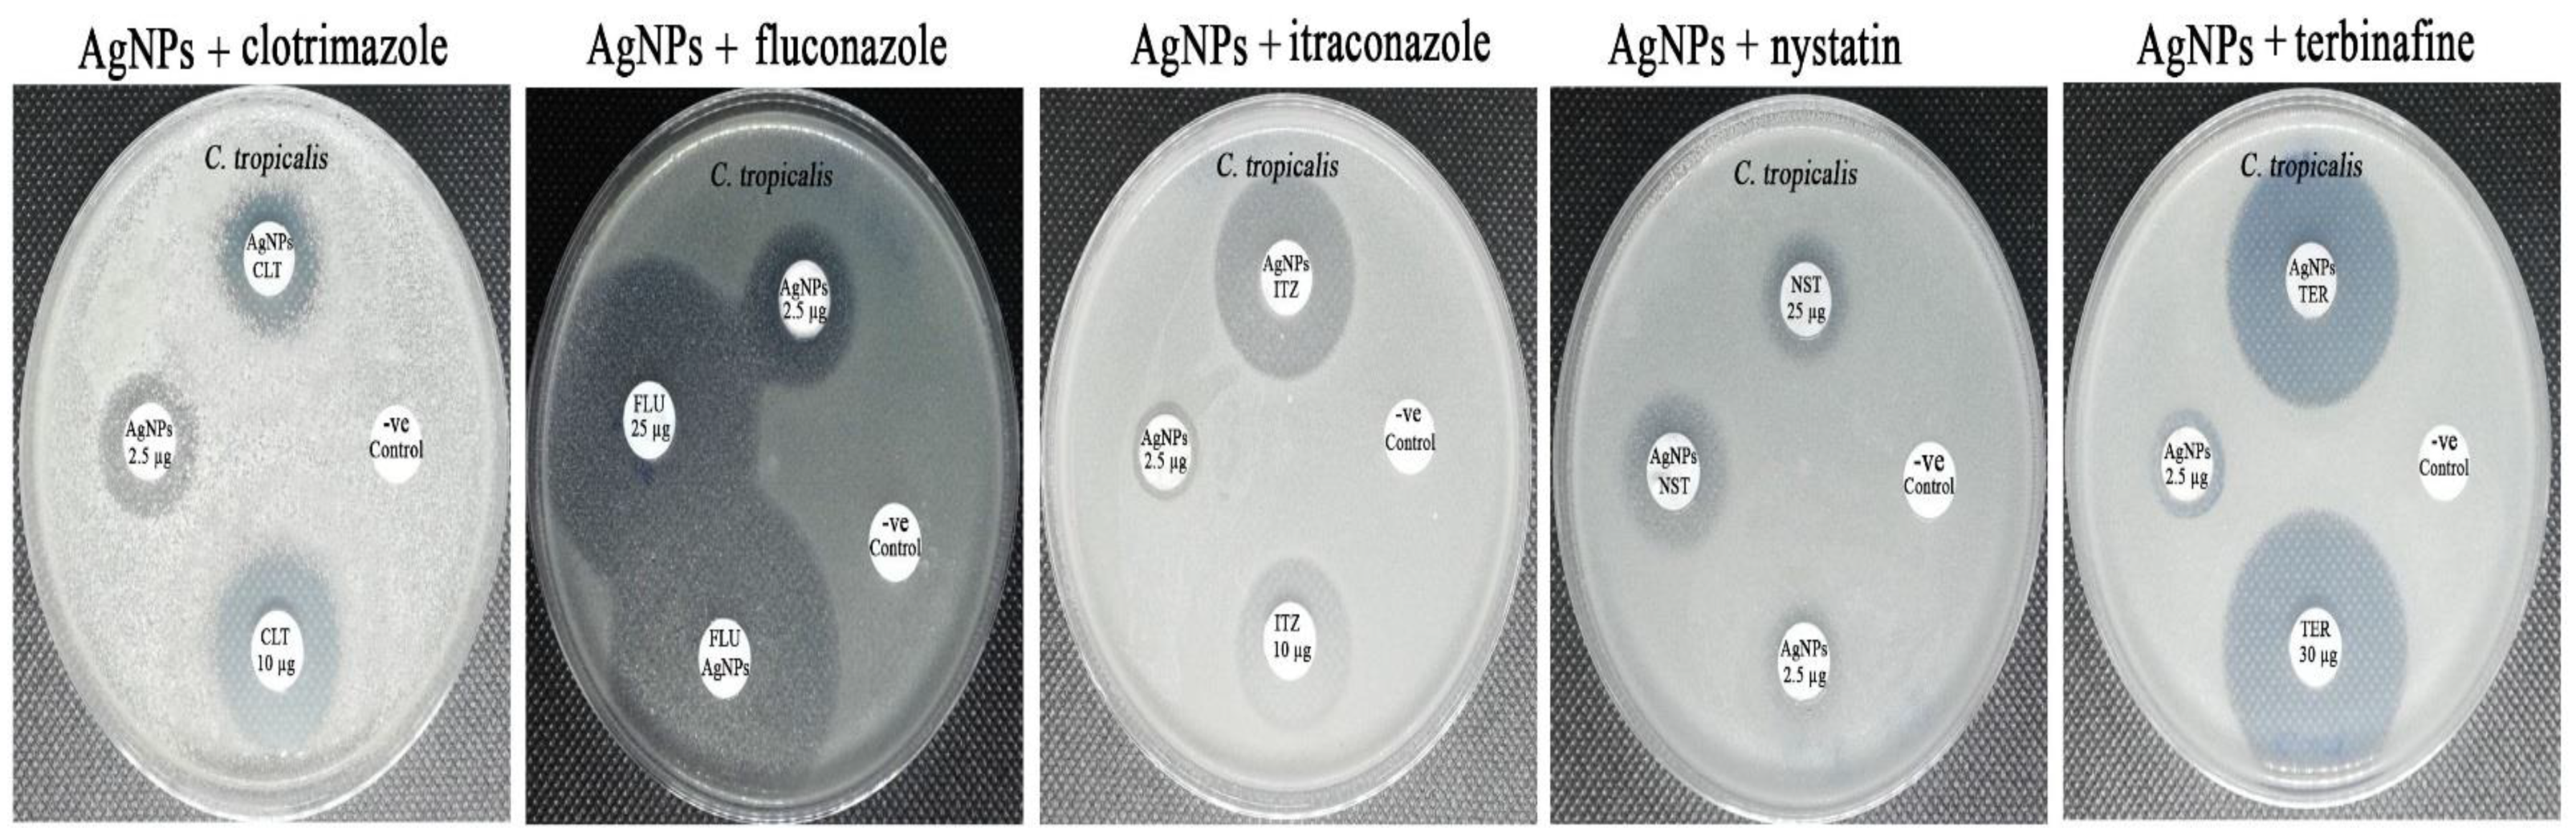
Crystals 12 00816 g011

Synergistic Antifungal Efficiency of Biogenic Silver Nanoparticles with Itraconazole against Multidrug-Resistant Candidal Strains
Abstract
:1. Introduction
2. Materials and Methods
2.1. Preparation of Pomegranate Extract
2.2. Green Synthesis of Silver Nanoparticles
2.3. Characterization of the Biosynthesized AgNPs
2.4. Screening of Anticandidal Efficiency of Biogenic AgNPs
2.5. Determination of Synergistic Activity of Biogenic AgNPs with Common Antifungal Drugs
2.6. Statistical Analysis
3. Results and Discussion
3.1. UV–Vis Spectral Analysis
3.2. TEM Characterization of the Biogenic Silver Nanoparticles
3.3. FTIR Analysis of the Biogenic Silver Nanoparticles
3.4. Edx Analysis of the Biosynthesized AgNPs
3.5. XRD Analysis of the Biogenic Silver Nanoparticles
3.6. Zeta Potential Analysis of the Biosynthesized Silver Nanoparticles
3.7. Screening of Anticandidal Activity of the Biogenic AgNPs
3.8. Synergistic Antifungal Activity of the Biogenic AgNPs with Commonly Used Antifungal Agents
4. Conclusions
Author Contributions
Funding
Data Availability Statement
Acknowledgments
Conflicts of Interest
References
- Rubey, K.M.; Brenner, J.S. Nanomedicine to fight infectious disease. Adv. Drug Deliv. Rev. 2021, 179, 113996. [Google Scholar] [CrossRef] [PubMed]
- Bongomin, F.; Gago, S.; Oladele, R.O.; Denning, D.W. Global and multi-national prevalence of fungal diseases—Estimate precision. J. Fungi 2017, 3, 57. [Google Scholar] [CrossRef] [PubMed]
- Jorgensen, S.C.; Trinh, T.D.; Zasowski, E.J.; Lagnf, A.M.; Simon, S.P.; Bhatia, S.; Melvin, S.M.; Steed, M.E.; Finch, N.A.; Morrisette, T.; et al. Real-world experience with ceftolozane-tazobactam for multidrug-resistant gram-negative bacterial infections. Antimicrob. Agents Chemother. 2020, 64, e02291-19. [Google Scholar] [CrossRef] [PubMed]
- Francesconi, F.; Jalkh, A.P.; Lupi, O.; Khalfe, Y. Mechanisms of Antifungal Drug Resistance Overcoming Antimicrobial Resistance of the Skin; Springer: Berlin/Heidelberg, Germany, 2021; pp. 133–142. [Google Scholar]
- Ibe, C.; Oladele, R.O.; Alamir, O. Our pursuit for effective antifungal agents targeting fungal cell wall components: Where are we? Int. J. Antimicrob. Agents 2021, 59, 106477. [Google Scholar] [CrossRef]
- Allen, D.; Wilson, D.; Drew, R.; Perfect, J. Azole antifungals: 35 years of invasive fungal infection management. Expert Rev. Anti-Infect. Ther. 2015, 13, 787–798. [Google Scholar] [CrossRef]
- Sardari, A.; Zarrinfar, H.; Mohammadi, R. Detection of ERG11 point mutations in Iranian fluconazole-resistant Candida albicans isolates. Curr. Med. Mycol. 2019, 5, 7. [Google Scholar]
- Lee, Y.; Puumala, E.; Robbins, N.; Cowen, L.E. Antifungal drug resistance: Molecular mechanisms in Candida albicans and beyond. Chem. Rev. 2020, 121, 3390–3411. [Google Scholar] [CrossRef]
- Bhattacharya, S.; Sae-Tia, S.; Fries, B.C. Candidiasis and mechanisms of antifungal resistance. Antibiotics 2020, 9, 312. [Google Scholar] [CrossRef]
- Nishimoto, A.T.; Sharma, C.; Rogers, P.D. Molecular and genetic basis of azole antifungal resistance in the opportunistic pathogenic fungus Candida albicans. J. Antimicrob. Chemother. 2020, 75, 257–270. [Google Scholar] [CrossRef]
- Revie, N.M.; Iyer, K.R.; Robbins, N.; Cowen, L.E. Antifungal drug resistance: Evolution, mechanisms and impact. Curr. Opin. Microbiol. 2018, 45, 70–76. [Google Scholar] [CrossRef]
- Robbins, N.; Cowen, L.E. Antifungal drug resistance: Deciphering the mechanisms governing multidrug resistance in the fungal pathogen Candida glabrata. Curr. Biol. 2021, 31, R1520–R1523. [Google Scholar] [CrossRef]
- Pinto, M.; Borges, V.; Nascimento, M.; Martins, F.; Pessanha, M.A.; Faria, I.; Rodrigues, J.; Matias, R.; Gomes, J.P.; Jordao, L. Insights on catheter-related bloodstream infections: A prospective observational study on the catheter colonization and multidrug resistance. J. Hosp. Infect. 2022, 123, 43–51. [Google Scholar] [CrossRef]
- Gheorghe, D.C.; Niculescu, A.-G.; Bîrcă, A.C.; Grumezescu, A.M. Biomaterials for the prevention of oral candidiasis development. Pharmaceutics 2021, 13, 803. [Google Scholar] [CrossRef]
- Dey, N.; Kamatchi, C.; Vickram, A.S.; Anbarasu, K.; Thanigaivel, S.; Palanivelu, J.; Pugazhendhi, A.; Ponnusamy, V.K. Role of nanomaterials in deactivating multiple drug resistance efflux pumps—A review. Environ. Res. 2022, 204, 111968. [Google Scholar] [CrossRef]
- Behzad, F.; Naghib, S.M.; Tabatabaei, S.N.; Zare, Y.; Rhee, K.Y. An overview of the plant-mediated green synthesis of noble metal nanoparticles for antibacterial applications. J. Ind. Eng. Chem. 2021, 94, 92–104. [Google Scholar] [CrossRef]
- Carrillo-González, R.; Martínez-Gómez, M.A.; González-Chávez, M.d.C.A.; Hernández, J.C.M. Inhibition of microorganisms involved in deterioration of an archaeological site by silver nanoparticles produced by a green synthesis method. Sci. Total Environ. 2016, 565, 872–881. [Google Scholar] [CrossRef]
- Yaqoob, A.A.; Umar, K.; Ibrahim, M.N.M. Silver nanoparticles: Various methods of synthesis, size affecting factors and their potential applications–a review. Appl. Nanosci. 2020, 10, 1369–1378. [Google Scholar] [CrossRef]
- Paul, S.; Mohanram, K.; Kannan, I. Antifungal activity of curcumin-silver nanoparticles against fluconazole-resistant clinical isolates of Candida species. Ayu 2018, 39, 182. [Google Scholar] [CrossRef]
- Iravani, S.; Korbekandi, H.; Mirmohammadi, S.V.; Zolfaghari, B. Synthesis of silver nanoparticles: Chemical, physical and biological methods. Res. Pharm. Sci. 2014, 9, 385. [Google Scholar]
- Hebbalalu, D.; Lalley, J.; Nadagouda, M.N.; Varma, R.S. Greener techniques for the synthesis of silver nanoparticles using plant extracts, enzymes, bacteria, biodegradable polymers, and microwaves. ACS Sustain. Chem. Eng. 2013, 1, 703–712. [Google Scholar] [CrossRef]
- Jeevanandam, J.; Kiew, S.F.; Boakye-Ansah, S.; Lau, S.Y.; Barhoum, A.; Danquah, M.K.; Rodrigues, J. Green approaches for the synthesis of metal and metal oxide nanoparticles using microbial and plant extracts. Nanoscale 2022, 14, 2534–2571. [Google Scholar] [CrossRef] [PubMed]
- Shreyash, N.; Bajpai, S.; Khan, M.A.; Vijay, Y.; Tiwary, S.K.; Sonker, M. Green synthesis of nanoparticles and their biomedical applications: A review. ACS Appl. Nano Mater. 2021, 4, 11428–11457. [Google Scholar] [CrossRef]
- Kumar, S.; Basumatary, I.B.; Sudhani, H.P.; Bajpai, V.K.; Chen, L.; Shukla, S.; Mukherjee, A. Plant extract mediated silver nanoparticles and their applications as antimicrobials and in sustainable food packaging: A state-of-the-art review. Trends Food Sci. Technol. 2021, 112, 651–666. [Google Scholar] [CrossRef]
- Perfect, J.R.; Ghannoum, M. Emerging issues in antifungal resistance. Infect Dis. Clin. 2020, 34, 921–943. [Google Scholar] [CrossRef]
- Sousa, F.; Ferreira, D.; Reis, S.; Costa, P. Current insights on antifungal therapy: Novel nanotechnology approaches for drug delivery systems and new drugs from natural sources. Pharmaceuticals 2020, 13, 248. [Google Scholar] [CrossRef]
- Ijaz, M.; Zafar, M.; Iqbal, T. Green synthesis of silver nanoparticles by using various extracts: A review. Inorg. Nano Met. Chem. 2020, 51, 744–755. [Google Scholar] [CrossRef]
- Monteiro, D.R.; Silva, S.; Negri, M.; Gorup, L.F.; de Camargo, E.R.; Oliveira, R.; Barbosa, D.B.; Henriques, M. Antifungal activity of silver nanoparticles in combination with nystatin and chlorhexidine digluconate against Candida albicans and Candida glabrata biofilms. Mycoses 2013, 56, 672–680. [Google Scholar] [CrossRef]
- Jia, D.; Sun, W. Silver nanoparticles offer a synergistic effect with fluconazole against fluconazole-resistant Candida albicans by abrogating drug efflux pumps and increasing endogenous ROS. Infect. Genet. Evol. 2021, 93, 104937. [Google Scholar] [CrossRef]
- Falcão, C.M.C.; Andrade, A.; Holanda, V.N.; de Figueiredo, R.C.B.Q.; Ximenes, E.A.; Gomes, A.S.L. Activity of poly(methacrylic acid)-silver nanoparticles on fluconazole-resistant Candida albicans strains: Synergistic and cytotoxic effects. J. Appl. Microbiol. 2022, 132, 4300–4309. [Google Scholar] [CrossRef]
- Shi, C.; Liu, J.; Li, W.; Zhao, Y.; Meng, L.; Xiang, M. Expression of fluconazole resistance-associated genes in biofilm from 23 clinical isolates of Candida albicans. Braz. J. Microbiol. 2019, 50, 157–163. [Google Scholar] [CrossRef]
- Yassin, M.T.; Mostafa, A.A.; Al-Askar, A.A.; Bdeer, R. In vitro antifungal resistance profile of Candida strains isolated from Saudi women suffering from vulvovaginitis. Eur. J. Med. Res. 2020, 25, 1. [Google Scholar] [CrossRef]
- Sakagami, T.; Kawano, T.; Yamashita, K.; Yamada, E.; Fujino, N.; Kaeriyama, M.; Fukuda, Y.; Nomura, N.; Mitsuyama, J.; Suematsu, H.; et al. Antifungal susceptibility trend and analysis of resistance mechanism for Candida species isolated from bloodstream at a Japanese university hospital. J. Infect. Chemother. 2019, 25, 34–40. [Google Scholar] [CrossRef] [Green Version]
- Aldardeer, N.F.; Albar, H.; Al-Attas, M.; Eldali, A.; Qutub, M.; Hassanien, A.; Alraddadi, B. Antifungal resistance in patients with Candidaemia: A retrospective cohort study. BMC Infect. Dis. 2020, 20, 55. [Google Scholar] [CrossRef] [Green Version]
- Yassin, M.T.; Mostafa, A.A.F.; Al-Askar, A.A.; Al-Otibi, F.O. Facile Green Synthesis of Silver Nanoparticles Using Aqueous Leaf Extract of Origanum majorana with Potential Bioactivity against Multidrug Resistant Bacterial Strains. Crystals 2022, 12, 603. [Google Scholar] [CrossRef]
- Rao, B.; Tang, R.-C. Green synthesis of silver nanoparticles with antibacterial activities using aqueous Eriobotrya japonica leaf extract. Adv. Nat. Sci. Nanosci. Nanotechnol. 2017, 8, 015014. [Google Scholar] [CrossRef] [Green Version]
- Khan, M.; Karuppiah, P.; Alkhathlan, H.Z.; Kuniyil, M.; Khan, M.; Adil, S.F.; Shaik, M.R. Green Synthesis of Silver Nanoparticles Using Juniperus procera Extract: Their Characterization, and Biological Activity. Crystals 2022, 12, 420. [Google Scholar] [CrossRef]
- Ahmed, F.; AlOmar, S.Y.; Albalawi, F.; Arshi, N.; Dwivedi, S.; Kumar, S.; Shaalan, N.M.; Ahmad, N. Microwave Mediated Fast Synthesis of Silver Nanoparticles and Investigation of Their Antibacterial Activities for Gram-Positive and Gram-Negative Microorganisms. Crystals 2021, 11, 666. [Google Scholar] [CrossRef]
- Yi, Y.; Wang, C.; Cheng, X.; Yi, K.; Huang, W.; Yu, H. Biosynthesis of Silver Nanoparticles by Conyza canadensis and Their Antifungal Activity against Bipolaris maydis. Crystals 2021, 11, 1443. [Google Scholar] [CrossRef]
- CLSI. Method for Antifungal Disk Diffusion Susceptibility Testing of Yeasts; CLSI m44-a; Clinical and Laboratory Standards Institute: Wayne, PA, USA, 2004; Volume 23. [Google Scholar]
- CLSI. Performance Standards for Antifungal Susceptibility Testing of Yeasts, CLSI Supplement m60, 1st ed.; Clinical and Laboratory Standards Institute: Wayne, PA, USA, 2017. [Google Scholar]
- Yassin, M.T.; Mostafa, A.A.F.; Al Askar, A.A. In Vitro Evaluation of Biological Activities and Phytochemical Analysis of Different Solvent Extracts of Punica granatum L. (Pomegranate) Peels. Plants 2021, 10, 2742. [Google Scholar] [CrossRef]
- Singh, R.; Wagh, P.; Wadhwani, S.; Gaidhani, S.; Kumbhar, A.; Bellare, J.; Chopade, B.A. Synthesis, optimization, and charac- terization of silver nanoparticles from Acinetobacter calcoaceticus and their enhanced antibacterial activity when combined with antibiotics. Int. J. Nanomed. 2013, 8, 4277. [Google Scholar]
- Huang, W.; Yan, M.; Duan, H.; Bi, Y.; Cheng, X.; Yu, H. Synergistic antifungal activity of green synthesized silver nanoparticles and epoxiconazole against Setosphaeria turcica. J. Nanomater. 2020, 2020, 9535432. [Google Scholar] [CrossRef] [Green Version]
- Lo, W.H.; Deng, F.S.; Chang, C.J.; Lin, C.H. Synergistic antifungal activity of chitosan with fluconazole against Candida albi- cans, Candida tropicalis, and fluconazole-resistant strains. Molecules 2020, 25, 5114. [Google Scholar] [CrossRef] [PubMed]
- Moteriya, P.; Padalia, H.; Chanda, S. Characterization, synergistic antibacterial and free radical scavenging efficacy of silver nanoparticles synthesized using Cassia roxburghii leaf extract. J. Genet. Eng. Biotechnol. 2017, 15, 505–513. [Google Scholar] [CrossRef] [PubMed]
- Zia, M.; Gul, S.; Akhtar, J.; Ul Haq, I.; Abbasi, B.H.; Hussain, A.; Naz, S.; Chaudhary, M.F. Green synthesis of silver nanoparticles from grape and tomato juices and evaluation of biological activities. IET Nanobiotechnol. 2017, 11, 193–199. [Google Scholar] [CrossRef]
- Bélteky, P.; Rónavári, A.; Zakupszky, D.; Boka, E.; Igaz, N.; Szerencsés, B.; Pfeiffer, I.; Vágvölgyi, C.; Kiricsi, M.; Kónya, Z. Are smaller nanoparticles always better? Understanding the biological effect of size-dependent silver nanoparticle aggregation under biorelevant conditions. Int. J. Nanomed. 2021, 16, 3021. [Google Scholar] [CrossRef]
- Shehabeldine, A.M.; Elbahnasawy, M.A.; Hasaballah, A.I. Green phytosynthesis of silver nanoparticles using echinochloa stagnina extract with reference to their antibacterial, cytotoxic, and larvicidal activities. BioNanoScience 2021, 11, 526–538. [Google Scholar] [CrossRef]
- Vallinayagam, S.; Rajendran, K.; Sekar, V. Green synthesis and characterization of silver nanoparticles using Naringi crenulate leaf extract: Key challenges for anticancer activities. J. Mol. Struct. 2021, 1243, 130829. [Google Scholar] [CrossRef]
- Mortazavi-Derazkola, S.; Ebrahimzadeh, M.A.; Amiri, O.; Goli, H.R.; Rafiei, A.; Kardan, M.; Salavati-Niasari, M. Facile green synthesis and characterization of Crataegus microphylla extract-capped silver nanoparticles (CME@ Ag-NPs) and its potential antibacterial and anticancer activities against AGS and MCF-7 human cancer cells. J. Alloys Compd. 2020, 820, 153186. [Google Scholar] [CrossRef]
- Restrepo, C.V.; Villa, C.C. Synthesis of silver nanoparticles, influence of capping agents, and dependence on size and shape: A review. Environ. Nanotechnol. Monit. Manag. 2021, 15, 100428. [Google Scholar] [CrossRef]
- Abdel-Raouf, N.; Al-Enazi, N.M.; Ibraheem, I.B.M.; Alharbi, R.M.; Alkhulaifi, M.M. Biosynthesis of silver nanoparticles by using of the marine brown alga Padina pavonia and their characterization. Saudi J. Biol. Sci. 2019, 26, 1207–1215. [Google Scholar] [CrossRef]
- Dada, A.O.; Adekola, F.A.; Dada, F.E.; Adelani-Akande, A.T.; Bello, M.O.; Okonkwo, C.R.; Inyinbor, A.A.; Oluyori, A.P.; Olayanju, A.; Ajanaku, K.O.; et al. Silver nanoparticle synthesis by Acalypha wilkesiana extract: Phytochemical screening, characterization, influence of operational parameters, and preliminary antibacterial testing. Heliyon 2019, 5, e02517. [Google Scholar] [CrossRef] [Green Version]
- Sila, M.J.; Nyambura, M.I.; Abong’o, D.A.; Mwaura, F.B.; Iwuoha, E. Biosynthesis of silver nanoparticles from Eucalyptus corymbia leaf extract at optimized conditions. In Nano Hybrids and Composites; Trans Tech Publications Ltd.: Zurich, Switzerland, 2019. [Google Scholar]
- Femi-Adepoju, A.G.; Dada, A.O.; Otun, K.O.; Adepoju, A.O.; Fatoba, O.P. Green synthesis of silver nanoparticles using terrestrial fern (Gleichenia Pectinata (Willd.) C. Presl.): Characterization and antimicrobial studies. Heliyon 2019, 5, e01543. [Google Scholar] [CrossRef] [Green Version]
- Al Aboody, M.S. Silver/silver chloride (Ag/AgCl) nanoparticles synthesized from Azadirachta indica lalex and its antibiofilm activity against fluconazole resistant Candida tropicalis. Artif. Cells Nanomed. Biotechnol. 2019, 47, 2107–2113. [Google Scholar] [CrossRef] [Green Version]
- Devanesan, S.; AlSalhi, M.S.; Balaji, R.V.; Ranjitsingh, A.J.A.; Ahamed, A.; Alfuraydi, A.A.; AlQahtani, F.Y.; Aleanizy, F.S.; Othman, A.H. Antimicrobial and cytotoxicity effects of synthesized silver nanoparticles from Punica granatum peel extract. Nanoscale Res. Lett. 2018, 13, 315. [Google Scholar] [CrossRef] [Green Version]
- Soliman, A.M.; Abdel-Latif, W.; Shehata, I.H.; Fouda, A.; Abdo, A.M.; Ahmed, Y.M. Green approach to overcome the resistance pattern of Candida spp. using biosynthesized silver nanoparticles fabricated by Penicillium chrysogenum F9. Biol. Trace Elem. Res. 2021, 199, 800–811. [Google Scholar] [CrossRef]
- Estevez, M.B.; Casaux, M.L.; Fraga, M.; Faccio, R.; Alborés, S. Biogenic silver nanoparticles as a strategy in the fight against multi-resistant salmonella enterica isolated from dairy calves. Front. Bioeng. Biotechnol. 2021, 9, 314. [Google Scholar] [CrossRef]
- Salleh, M.S.N.; Ali, R.R.; Shameli, K.; Hamzah, M.Y.; Kasmani, R.M.; Nasef, M.M. Interaction Insight of Pullulan-Mediated Gamma-Irradiated Silver Nanoparticle Synthesis and Its Antibacterial Activity. Polymers 2021, 13, 3578. [Google Scholar] [CrossRef]
- Hawar, S.N.; Al-Shmgani, H.S.; Al-Kubaisi, Z.A.; Sulaiman, G.M.; Dewir, Y.H.; Rikisahedew, J.J. Green Synthesis of Silver Nanoparticles from Alhagi graecorum Leaf Extract and Evaluation of Their Cytotoxicity and Antifungal Activity. J. Nanomater. 2022, 2022, 1058119. [Google Scholar] [CrossRef]
- Endo, E.H.; Cortez, D.A.G.; Ueda-Nakamura, T.; Nakamura, C.V.; Dias Filho, B.P. Potent antifungal activity of extracts and pure compound isolated from pomegranate peels and synergism with fluconazole against Candida albicans. Res. Microbiol. 2010, 161, 534–540. [Google Scholar] [CrossRef]
- Ali, S.; Sulaiman, S.; Khan, A.; Khan, M.R.; Khan, R. Green synthesized silver nanoparticles (AgNPs) from Parrotiopsis jacquemontiana (Decne) Rehder leaf extract and its biological activities. Microsc. Res. Tech. 2022, 85, 28–43. [Google Scholar] [CrossRef]
- Sharifi-Rad, M.; Pohl, P. Synthesis of biogenic silver nanoparticles (Agcl-NPs) using a pulicaria vulgaris gaertn. aerial part extract and their application as antibacterial, antifungal and antioxidant agents. Nanomaterials 2020, 10, 638. [Google Scholar] [CrossRef] [PubMed] [Green Version]
- Pote, S.T.; Sonawane, M.S.; Rahi, P.; Shah, S.R.; Shouche, Y.S.; Patole, M.S.; Thakar, M.R.; Sharma, R. Distribution of pathogenic yeasts in different clinical samples: Their identification, antifungal susceptibility pattern, and cell invasion assays. Infect Drug Resist. 2020, 13, 1133. [Google Scholar] [CrossRef] [Green Version]
- Padalia, H.; Moteriya, P.; Chanda, S. Green synthesis of silver nanoparticles from marigold flower and its synergistic antimicrobial potential. Arab. J. Chem. 2015, 8, 732–741. [Google Scholar] [CrossRef] [Green Version]
- Aabed, K.; Mohammed, A.E. Synergistic and Antagonistic Effects of Biogenic Silver Nanoparticles in Combination With Antibiotics Against Some Pathogenic Microbes. Front. Bioeng. Biotechnol. 2021, 9, 249. [Google Scholar] [CrossRef]
- Rudramurthy, G.R.; Swamy, M.K. Potential applications of engineered nanoparticles in medicine and biology: An update. J. Biol. Inorg. Chem. 2018, 23, 1185–1204. [Google Scholar] [CrossRef]
- Tang, S.; Zheng, J. Antibacterial activity of silver nanoparticles: Structural effects. Adv. Healthc. Mater. 2018, 7, 1701503. [Google Scholar] [CrossRef]
- Cai, X.; Liu, X.; Jiang, J.; Gao, M.; Wang, W.; Zheng, H.; Xu, S.; Li, R. Molecular mechanisms, characterization methods, and utilities of nanoparticle biotransformation in nanosafety assessments. Small 2020, 16, 1907663. [Google Scholar] [CrossRef]
- Dar, M.A.; Ingle, A.; Rai, M. Enhanced antimicrobial activity of silver nanoparticles synthesized by Cryphonectria sp. evaluated singly and in combination with antibiotics. Nanomed. Nanotechnol. Biol. Med. 2013, 9, 105–110. [Google Scholar] [CrossRef]
- Sun, L.; Liao, K.; Li, Y.; Zhao, L.; Liang, S.; Guo, D.; Hu, J.; Wang, D. Synergy between polyvinylpyrrolidone-coated silver nanoparticles and azole antifungal against drug-resistant Candida albicans. J. Nanosci. Nanotechnol. 2016, 16, 2325–2335. [Google Scholar] [CrossRef]
- Li, H.; Wang, L.; Chai, Y.; Cao, Y.; Lu, F. Synergistic effect between silver nanoparticles and antifungal agents on Candida albicans revealed by dynamic surface-enhanced Raman spectroscopy. Nanotoxicology 2018, 12, 1230–1240. [Google Scholar] [CrossRef]
- Ivanov, M.; Ćirić, A.; Stojković, D. Emerging Antifungal Targets and Strategies. Int. J. Mol. Sci. 2022, 23, 2756. [Google Scholar] [CrossRef] [PubMed]
- Nisar, P.; Ali, N.; Rahman, L.; Ali, M.; Shinwari, Z.K. Antimicrobial activities of biologically synthesized metal nanoparticles: An insight into the mechanism of action. JBIC J. Biol. Inorg. Chem. 2019, 24, 929–941. [Google Scholar] [CrossRef] [PubMed]

| No. | Absorption Peak (cm−1) | Appearance | Functional Groups | Molecular Motion |
|---|---|---|---|---|
| 1 | 3434.45 | Strong, broad | Alcohols and phenols | O-H stretching |
| 2 | 1695.50 | Medium | Conjugated aldehyde | C=O stretching |
| 3 | 1626.46 | Medium | Conjugated alkene | C=C stretching |
| 4 | 1448.63 | Medium | Aromatic group | C-H bending |
| 5 | 1339.07 | Medium | Amine | C-N stretching |
| 6 | 1112.58 | Medium | Amine | C-N stretching |
| 7 | 1056.97 | Medium | Amine | C-N stretching |
| 8 | 757.71 | Weak | Aromatic group | C-H bending |
| 9 | 579.43 | Strong, broad | Halo compound | C-Br stretching |
| Concentration (µg/Disk) | Inhibition Zone Diameter (mm) | ||
|---|---|---|---|
| C. albicans | C. glabrata | C. tropicalis | |
| AgNPs (50 µg/disk) | 18.13 ± 0.46 | 13.89 ± 0.45 | 20.67 ± 0.41 |
| AgNPs (100 µg/disk) | 21.38 ± 0.58 | 16.53 ± 0.21 | 23.78 ± 0.63 |
| APPE extract (100 µg/disk) | 0.00 ± 0.00 | 0.00 ± 0.00 | 0.00 ± 0.00 |
| Terbinafine (50 µg/disk) | 28.53 ± 0.23 | 8.91 ± 0.35 | 34.63 ± 0.46 |
| (-ve) control | 0.00 ± 0.00 | 0.00 ± 0.00 | 0.00 ± 0.00 |
| Concentrations (µg/Disk) | Inhibition Zone Diameter (mm) | |||||
|---|---|---|---|---|---|---|
| C. albicans | C. glabrata | C. tropicalis | S | I | R | |
| CLO (10 µg) | 24.68 ± 0.34 | 35.89 ± 0.32 | 23.89 ± 0.45 | ≥20 | 12–19 | <11 |
| CLO (10 µg) + AgNPs (2.5 µg) | 24.78 ± 0.15 | 27.91 ± 0.42 | 17.78 ± 0.36 | |||
| FLU (25 µg) | 45.31 ± 0.12 | 22.12 ± 0.17 | 43.56 ± 0.41 | ≥22 | 15–21 | <14 |
| FLU (25 µg) + AgNPs (2.5 µg) | 34.41 ± 0.16 | 19.34 ± 0.23 | 37.45 ± 0.26 | |||
| ITZ (10 µg) | 38.23 ± 0.31 | 8.01 ± 0.07 | 20.92 ± 0.31 | ≥23 | 14–22 | <13 |
| ITZ (10 µg) + AgNPs (2.5 µg) | 24.26 ± 0.25 | 14.12 ± 0.36 | 29.78 ± 0.20 | |||
| NST (25 µg) | 32.16 ± 0.47 | 0.00 ± 0.00 | 15.89 ± 0.36 | ≥15 | 10–19 | <10 |
| NST (25 µg) + AgNPs (2.5 µg) | 42.14 ± 0.36 | 0.00 ± 0.00 | 22.67 ± 0.24 | |||
| TER (30 µg) | 31.76 ± 0.51 | 8.21 ± 0.08 | 34.98 ± 0.27 | ≥20 | 12–19 | <11 |
| TER (30 µg) + AgNPs (2.5 µg) | 37.98 ± 0.43 | 12.89 ± 0.21 | 33.76 ± 0.13 | |||
Publisher’s Note: MDPI stays neutral with regard to jurisdictional claims in published maps and institutional affiliations. |
© 2022 by the authors. Licensee MDPI, Basel, Switzerland. This article is an open access article distributed under the terms and conditions of the Creative Commons Attribution (CC BY) license (https://creativecommons.org/licenses/by/4.0/).
Share and Cite
Yassin, M.T.; Mostafa, A.A.-F.; Al-Askar, A.A.; Al-Otibi, F.O. Synergistic Antifungal Efficiency of Biogenic Silver Nanoparticles with Itraconazole against Multidrug-Resistant Candidal Strains. Crystals 2022, 12, 816. https://doi.org/10.3390/cryst12060816
Yassin MT, Mostafa AA-F, Al-Askar AA, Al-Otibi FO. Synergistic Antifungal Efficiency of Biogenic Silver Nanoparticles with Itraconazole against Multidrug-Resistant Candidal Strains. Crystals. 2022; 12(6):816. https://doi.org/10.3390/cryst12060816
Chicago/Turabian StyleYassin, Mohamed Taha, Ashraf Abdel-Fattah Mostafa, Abdulaziz Abdulrahman Al-Askar, and Fatimah O. Al-Otibi. 2022. "Synergistic Antifungal Efficiency of Biogenic Silver Nanoparticles with Itraconazole against Multidrug-Resistant Candidal Strains" Crystals 12, no. 6: 816. https://doi.org/10.3390/cryst12060816






